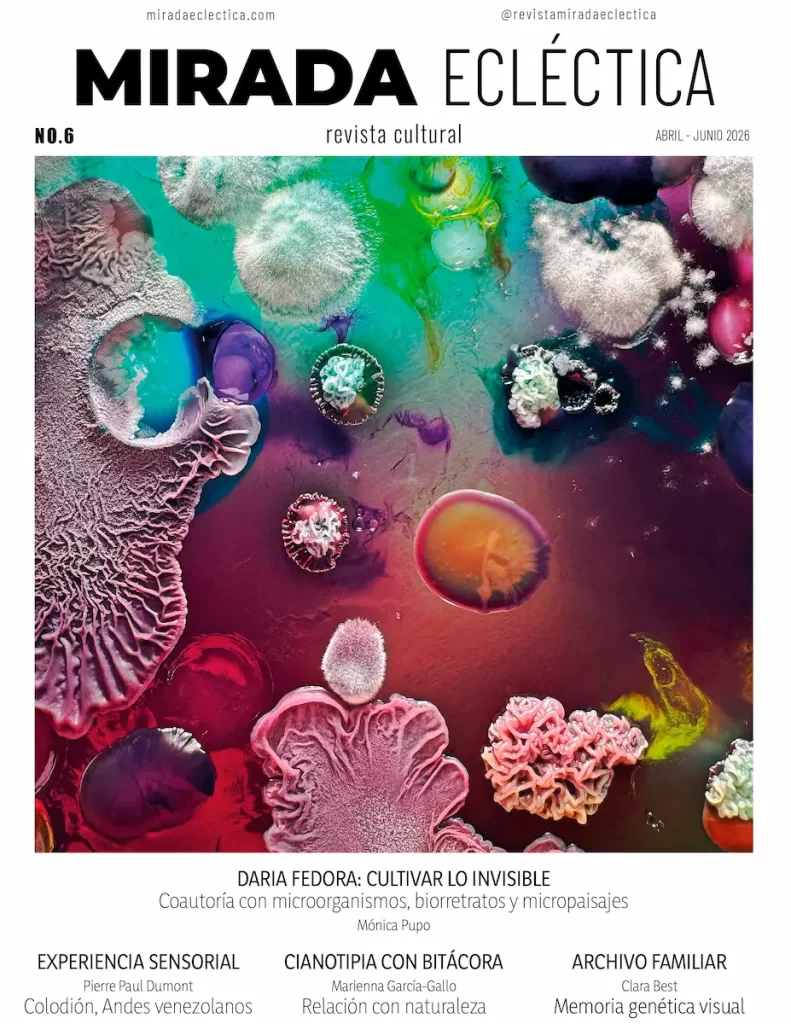

Debates, reflexiones y una mirada crítica sobre la fotografía y las diversas formas de arte como medios poderosos de expresión y comunicación.
GALERÍA
Luis Bisbal fue una de las figuras esenciales del fotoperiodismo venezolano, formado entre laboratorios de cine, redacciones y el vértigo de las coberturas en campo. En su mirada convivían el rigor técnico y la intuición del instante irrepetible. Más que registrar hechos, parecía detenerlos antes de que desaparecieran. “Un archivo fotográfico guarda la memoria de un país”, decía, como síntesis de un oficio entendido como forma de permanencia.
Su archivo fotográfico reúne escenas clave de la historia contemporánea venezolana e internacional: la visita del presidente francés Charles de Gaulle a Caracas en 1964; la del príncipe Carlos de Inglaterra, acompañado por Luis Teófilo Núñez Arismendi y Carlos Andrés Pérez; la caída de la cruz de la Catedral de Caracas sobre el piso; la visita de Indira Gandhi en 1968, recibida en La Casona junto a la primera dama doña Menca de Leoni; el funeral del expresidente Raúl Leoni en el Salón Elíptico del Congreso Nacional, donde amigos, familiares y allegados rodearon su ataúd; la visita del papa Juan Pablo II en 1985; el estallido social del Caracazo en 1989; y la presencia del explorador Jacques Cousteau, figura central del pensamiento ambiental del siglo XX.